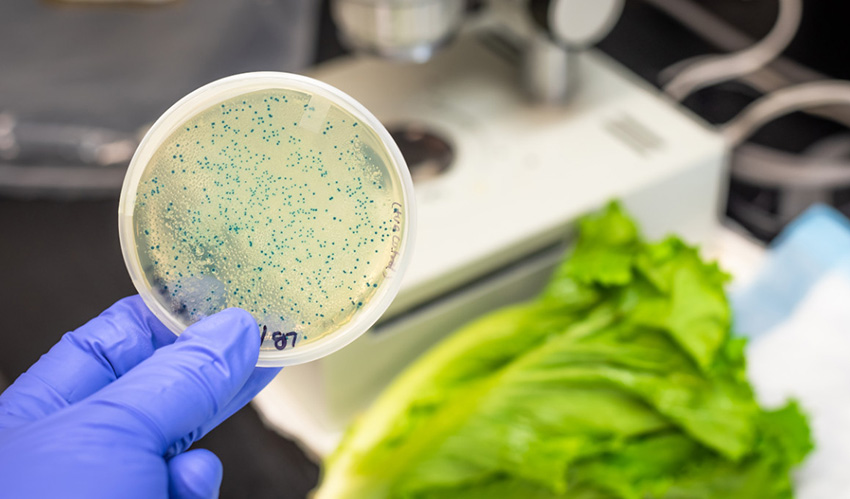
Escherichia Coli Nedir? Nasıl Korunulur?

Çocuğun Parmak Ucunda Yürümesi Ne Zaman Düzelir?
Çocuğun parmak ucunda yürümesi birçok farklı soruna bağlı olarak gelişebiliyor. Bu sorunun sebepleri, tedavi yöntemleri, nasıl düzelebileceği gibi birçok konuyu bu yazımızda anlattık. Bakalım çocuklarda parmak ucunda yürüme sebepleri neler?